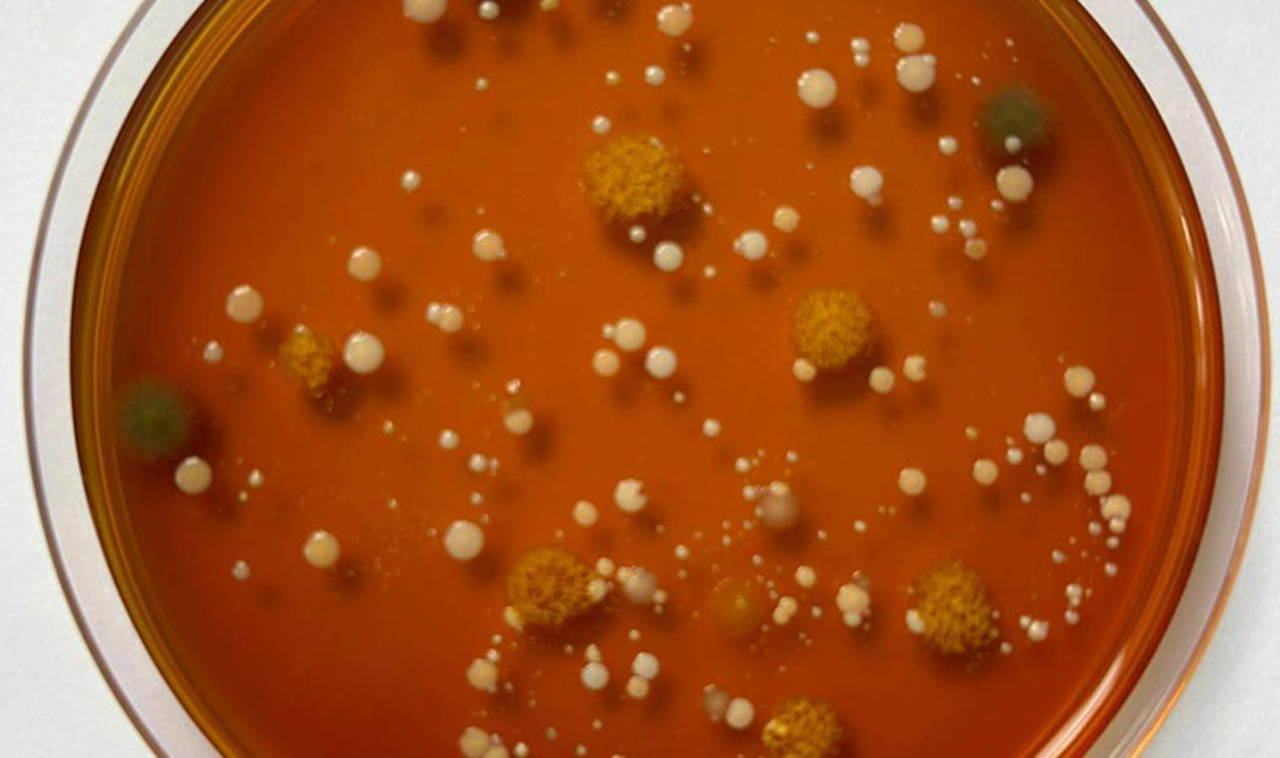
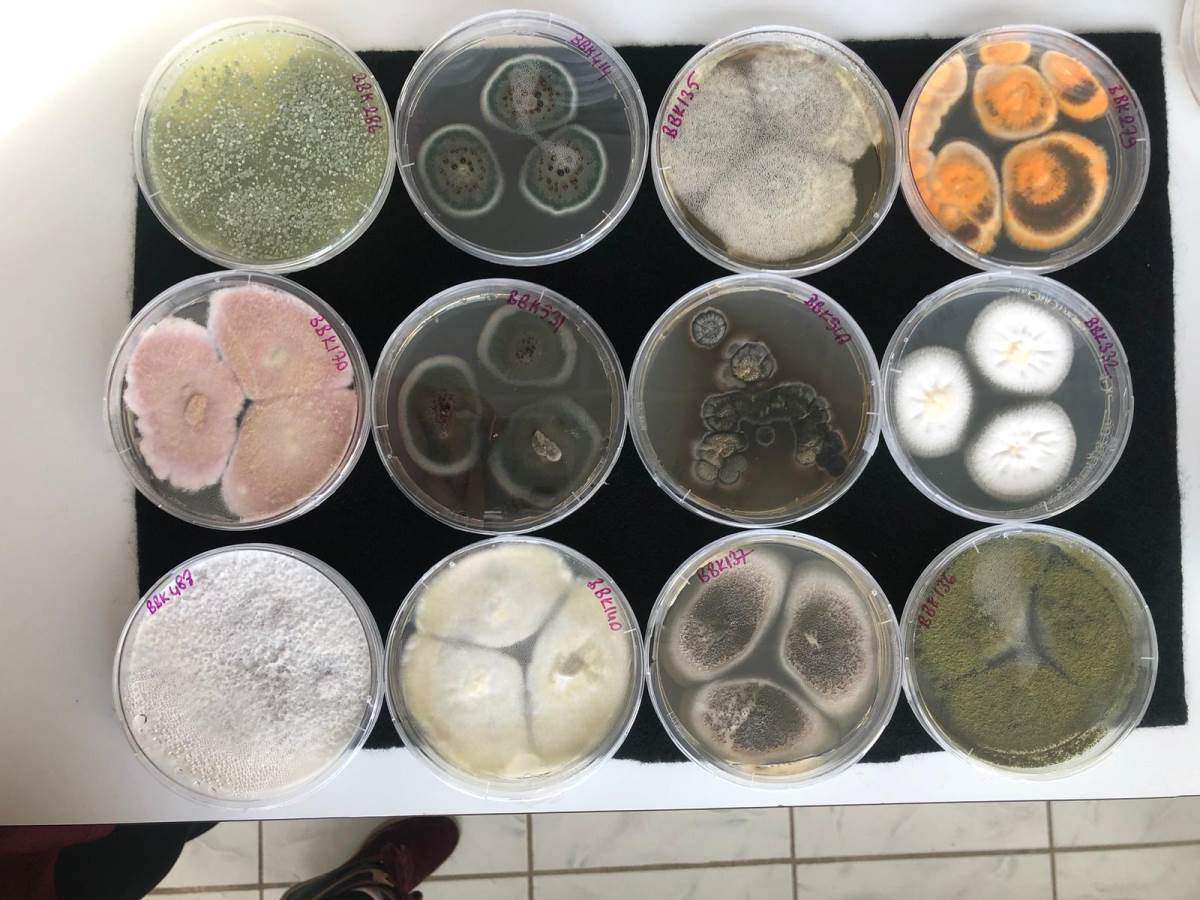

Çanakkale Onsekiz Mart Üniversitesinde (ÇOMÜ) yürütülen araştırmada, kullanılmış makyaj süngerlerinde cilt sağlığını tehdit eden bakteriler belirlendi.
ÇOMÜ Sağlık Hizmetleri Meslek Yüksekokulu Tıbbi Hizmetler ve Teknikler Bölümü Dr. Öğr. Üyesi Gülçin Özcan Ateş, Biyomühendislik Bölümü öğrencileri Gaye Su Yiğit ve Zeynep Turna ile "Makyaj Süngerlerinin Mikrobiyal Yüklerinin Belirlenmesi" adlı araştırma projesi yürüttü.

Üniversitenin Bilimsel Araştırma Projeleri Birimince desteklenen projede, kadınların makyaja ilgilerinden yola çıkan ekip, kozmetiğe yardımcı ürünlerin cilt sağlığına etkilerini ve hangi mikroorganizmaları barındırdığını araştırdı.

ÇARPICI SONUÇLAR!
Proje kapsamında 18 yaş üstü 26 katılımcıdan temin ettikleri makyaj süngerlerini laboratuvar ortamında inceleyen ekip, bu ürünlerin cilt enfeksiyonlarına, iltihaplı sivilceye neden olan, hatta biri dışkı kaynaklı mikroorganizmalar (bakteri, maya ve küf) barındırdığını belirledi.
Dr. Öğr. Üyesi Ateş, kozmetiğe yardımcı ürünlerin ilk aşamada steril üretilse bile kullanıldığı süreçte kontaminasyona (bozulma) maruz kaldığını söyledi.
Kozmetik ürünlerde E ve C vitaminleri, hyaluronik asit gibi besleyici maddelerin bulunduğunu belirten Ateş, "Bunlar zaten mikroorganizmaların gelişmesi için de önemli faktörler. Dolayısıyla biz kozmetik ürünü, makyaj süngerine uyguluyoruz, sonra elimizle tutuyoruz, çevreye dokunuyoruz. Dolayısıyla mikroorganizmaların gelişmesi için çok güzel bir ortam hazırlamış oluyoruz" dedi.
"CİDDİ ANLAMDA BAKTERİYAL YÜK KARŞIMIZA ÇIKTI"
Ateş, proje için ulaştıkları 26 katılımcıdan kullandıkları makyaj süngerlerini aldıklarını, bu kişilere mikrobiyal yükü etkileyebileceğini düşündükleri "Evde yıkama veya kurutma faktöründen etkileniyor mu?", "Nerede saklıyorsunuz?" gibi sorular yönelttiklerini aktardı.
Bu şekilde makyaj süngerlerinin mikrobiyal yüklerini değerlendirdiklerini vurgulayan Ateş, şöyle devam etti:
"Sonuçta ciddi anlamda bakteriyel yük karşımıza çıktı. Sadece bakteri değil bunun yanında küf ve maya da belirledik ama ciddi oranda bakteri yükümüz vardı. Özellikle staphyloccoccus (mikroskopta üzüm salkımlarına benzer kümeler durumunda görülen mikroplar, stafilokok) dediğimiz bakteriler çok yoğunluktaydı. Bu, cildimizde bulunan bir mikroorganizma ama bunun dışında, bağışıklık durumunun değişmesi, kişinin yaş ve özellikleri gibi farklı farklı faktörlerle insanlarda ciddi cilt enfeksiyonlarına, iltihaplı sivilceye sebep olan bakteri türlerini tespit ettik. Bununla birlikte 'enterobacteriaceae' dediğimiz bir familyamız var, özellikle dışkı kaynaklı kontaminasyon kaynağı olarak belirtebileceğimiz."

Ateş, kozmetik ürünlerin çoğunlukla banyolarda kullanıldığına, bu nedenle de hijyenin önemine işaret ederek, "El hijyenine dikkat etmediğimizden ya da malzeme banyoda düşünce yeniden kullanımından dolayı dışkı kaynaklı bakterilerin kontamine olduğunu tespit etmiş olduk. Bunları tamamen hayatımızdan çıkaramayız, kullanmaya devam edeceğiz ama ciddi anlamda temizlik koşullarına dikkat etmemiz lazım. O ürünü kullandıktan sonra yıkıyorsak, hızlı bir kurutma yapmamız lazım. Çünkü o yavaşladıkça, oradaki nem ve besleyici maddelerle mikroorganizma üremeye devam edecek ve her zaman daha fazla bakteriye maruz kalmış olacağız" diye konuştu.